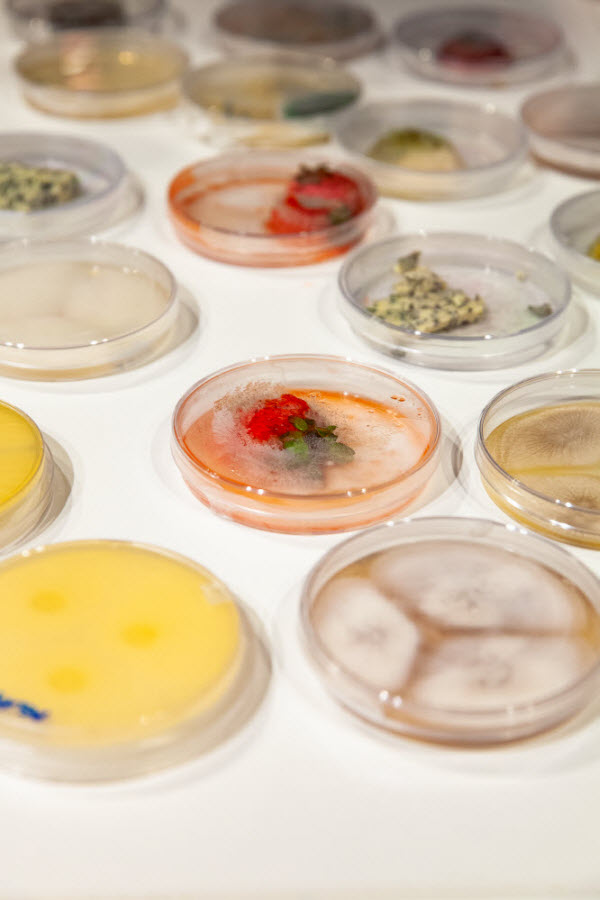

24.05.2022

Das war die Lange Nacht der Forschung 2022
Viele Fragen, staunende Gesichter und reichlich Forschung zum Angreifen – das war die Lange Nacht der Forschung 2022. 14.000 Besucher:innen nutzten in Tirol die Möglichkeit, Wissenschaft und Forschung hautnah zu erleben. Zahlreiche Forscher:innen und Mitarbeiter:innen der Medizin Uni Innsbruck boten im CCB, im Foyer der Fritz-Pregl-Straße 3, in der Anatomie und am Klinikareal faszinierende Einblicke in ihre Arbeit.
Die zehnte Lange Nacht der Forschung (LNF22) ging vergangenen Freitag österreichweit mit großem Andrang über die Bühne. Der Corona bedingten Online-Veranstaltung 2020 folgte nun wieder eine Präsentation von Wissenschaft und Forschung aus nächster Nähe. Unter den acht Tiroler Hochschulen bot die Medizin Uni Innsbruck auch dieses Mal wieder ein besonders abwechslungsreiches und innovatives Programm, das zwischen 17 und 23 Uhr in Form von Experimenten, Führungen, Workshops und Vorträgen besucht und absolviert werden konnte.
Der Ansturm auf die Platzkarten für die Führungen am Klinikareal war in diesem Jahr wie gewohnt groß. Auch sonst hatten unsere Forscher:innen und Mitarbeiter:innen viel zu tun, um das Interesse und die Neugierde des Publikums zu stillen. Dafür gebührt ihnen ein großes Dankeschön! Hier ein Rückblick in bewegten Bildern:
Auch unser Fotograf Chó hat die besonderen Momente der „Langen Nacht der Forschung“ an der Medizinischen Universität Innsbruck eingefangen. Alle Teams, die bei der LNF 2022 dabei waren, haben in Kürze die Möglichkeit, ihre Bilder herunterzuladen.
Hier eine erste Auswahl:

(24.05.2022, Text: D. Heidegger, Bilder: Chó / https://www.wefeel.art/ )